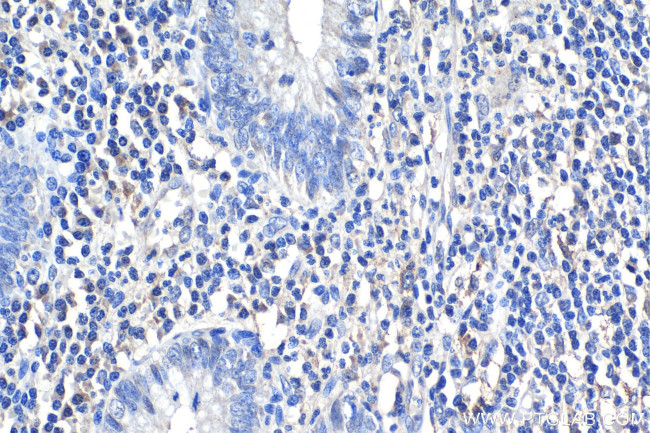
IL-1R1 Antibody in Immunohistochemistry (Paraffin) (IHC (P))

Search
Proteintech
IL-1R1 Polyclonal Antibody
{{$productOrderCtrl.translations['antibody.pdp.commerceCard.promotion.promotions']}}
{{$productOrderCtrl.translations['antibody.pdp.commerceCard.promotion.viewpromo']}}
{{$productOrderCtrl.translations['antibody.pdp.commerceCard.promotion.promocode']}}: {{promo.promoCode}} {{promo.promoTitle}} {{promo.promoDescription}}. {{$productOrderCtrl.translations['antibody.pdp.commerceCard.promotion.learnmore']}}
产品信息
27348-1-AP
种属反应
已发表种属
宿主/亚型
分类
类型
抗原
偶联物
形式
浓度
规格
纯化类型
保存液
内含物
保存条件
运输条件
产品详细信息
Immunogen sequence: LEADKCKERE EKIILVSSAN EIDVRPCPLN PNEHKGTITW YKDDSKTPVS TEQASRIHQH KEKLWFVPAK VEDSGHYYCV VRNSSYCLRI KISAKFVENE PNLCYNAQAI FKQKLPVAGD GGLVCPYMEF FKNENNELPK LQWYKDCKPL LLDNIHFSGV KDRLIVMNVA EKHRGNYTCH ASYTYLGKQY PITRVIEFIT LEENKPTRPV IVSPANETME VDLGSQIQLI CNVTGQLSDI AYWKWNGSVI DEDDPVLGED YYSVENPANK RRSTLITVLN ISEIESRFYK HPFTCFAKNT HGIDAAYIQL IYPVTNFQK
靶标信息
The IL-1 system includes two agonists (IL-1 and IL-1), converting enzymes, antagonists, two receptors (IL-1 RI and IL-1 RII) and the IL-1 receptor accessory protein. Interleukin-1 signal is transduced through the type I receptor.
仅用于科研。不用于诊断过程。未经明确授权不得转售。
生物信息学
蛋白别名: antigen CD121a; CD121 alpha; CD121 antigen-like family member A; CD121a; il-1 receptor; IL-1 receptor alpha chain; il-1r; IL-1R-1; IL-1R-alpha; IL-1RT-1; IL-1RT1; il1 receptor; interleukin 1 receptor alpha, type I; interleukin 1 receptor precursor; interleukin-1 receptor; Interleukin-1 receptor alpha; Interleukin-1 receptor type 1; Interleukin-1 receptor type I; p80; unnamed protein product
基因别名: CD121A; CD121b; CRMO3; D2S1473; IL-1R-alpha; IL-1R1; IL-1RT1; IL-iR; IL1R; Il1r-1; IL1R1; IL1RA; IL1RT1; P80
UniProt ID: (Human) P14778, (Mouse) P13504
Entrez Gene ID: (Human) 3554, (Mouse) 16177